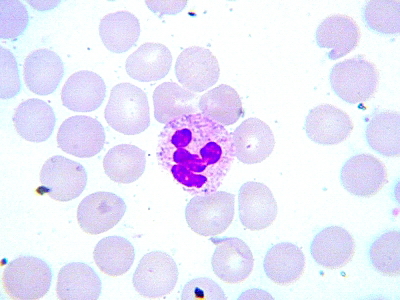
Удивительные фотографии под микроскопом 01 Ноябрь 2014 09:45 Удивительные фотографии под микроскопом 01 Ноябрь 2014 09:45

| Автор |
Сообщение |
|
Артем Астроскоп
|
|
Регистрация: 05 дек 2011 Посты: 1255
Vk:
|
Игорь Загинайло писал(а): Артем Астроскоп писал(а): Суперские фото, Вы микробиолог? Спасибо, Артем. Для суперских фото камера и оптика слабоваты - нужны камера с полноразмерной матрицей и план-апо оптика на бесконечность. Вот примеры таки суперских фото: Международный конкурс микрофотографий Olympus BioScapes 2013: http://www.olympusbioscapes.com/gallery/2013/ Международный конкурс микрофотографий Nikon Small World 2013: http://www.nikonsmallworld.com/gallerie ... ompetitionЯ не биолог. Любитель. Увлекся микроскопом всего пару лет назад назад. Еще парочку снимков: кристаллы, образованные на предметном стекле после высыхания растворов. Съемки в скрещенных поляроидах (поляризатор под конденсором, анализатор между объективом и вэб-камерой). Тем не менее за пару лет Вы достигли отличного результата.
|
|
|
|
|
|
|
Игорь Загинайло
|
|
Регистрация: 21 окт 2014 Посты: 83 Откуда: Одесса
Facebook:
|
Эпидерма листа герани. В центре фото железистый трихом (не от слова "желЕзо", а от слова "железА"). Окраска толуидиновым синим и хризоидином. Объектив 20х.
Обработка в SmartDeblur (свободно распространяемая версия 1.27). SmartDeblur может повысить резкость тех частей снимка, что "не попадают в глубину резкости", это иногда помогает. Но разрешение при этом страдает.
 Просмотров: 2191
|
|
|
|
|
|
|
|
Igor Tkachenko
|
|
Регистрация: 29 окт 2014 Посты: 31 Откуда: Киев
Facebook:
|
мазок крови окрашенный по Романовскому, объектив 90х, окуляр 10х, бинокулярная насадка 1.5х. иммерсионное масло на препарате, глицерин на конденсорной линзе, освещение светодиод, честно говоря стыдно показывать, но все же выложу  Просмотров: 2176
|
|
|
|
|
|
|
Игорь Загинайло
|
|
Регистрация: 21 окт 2014 Посты: 83 Откуда: Одесса
Facebook:
|
Igor Tkachenko писал(а): мазок крови окрашенный по Романовскому... Поздравляю, с первого раза не у всех и так выходит. Фиксировали в метиловом спирте? Пока что Вас ограничивает качество освещения. Кстати, у меня вид ненамного лучше:
Комментарий к файлу: Улыбающийся лимфоцит
Просмотров: 2174
|
|
|
|
|
|
|
|
Igor Tkachenko
|
|
Регистрация: 29 окт 2014 Посты: 31 Откуда: Киев
Facebook:
|
спасибо! фиксировал в изопропаноле, дома с метанолом возиться не хочу, т.к. делаю все на кухне. я бы сказал намного лучше у вас получилось:) посмотрел ролики про настройку света, но зеркала у меня пока нет и осветителя с диафрагмой тоже кстати левая часть изображения не в фокусе - подозреваю, что проблема в не родном предметном столике - направляющие пришлось убрать, а на болтах получилось закрепить его плоскость не перпендикулярно оптической оси.
|
|
|
|
|
|
|
Игорь Загинайло
|
|
Регистрация: 21 окт 2014 Посты: 83 Откуда: Одесса
Facebook:
|
Igor Tkachenko писал(а): ...фиксировал в изопропаноле... с метанолом возиться не хочу, т.к. делаю все на кухне... Тогда у ж лучше в этаноле. Тем более, что на кухне ему быть более естественно 
|
|
|
|
|
|
|
Igor Tkachenko
|
|
Регистрация: 29 окт 2014 Посты: 31 Откуда: Киев
Facebook:
|
оу, здесь два конца палки  в ипсе воды намного меньше, можно сказать практически нет, а в этаноле от нее тяжело избавиться
|
|
|
|
|
|
|
Игорь Загинайло
|
|
Регистрация: 21 окт 2014 Посты: 83 Откуда: Одесса
Facebook:
|
Для фиксации вода не помеха, тут главное - токсин, которым фиксируются, т.е. умершвляются клетки. Тем более, что мазок спева сушится, затем фиксируется, затем красится в водной среде, затем снова сушится.
|
|
|
|
|
|
|
Игорь Загинайло
|
|
Регистрация: 21 окт 2014 Посты: 83 Откуда: Одесса
Facebook:
|
Три снимка одного растения. Алоэ древовидный. Произрастает на подоконнике у каждого третьего домашнего цветовода.
Снимок 1. Поперечный срез "живого" листа. Окраска толуидиновым синим без предварительной фиксации. Толуидиновый синий может давать два цвета: собственно синий и фиолетовый. Синим окрасились клетки эпидермы и кутикула, сиреневым - паренхимальные клетки и проводящие пучки. Зеленые - хлоропласты. Объектив 20х/0,4.
Снимок 2. Поперечный срез листа, зафиксирован в смеси этилового спирта, формалина и уксусной к-ты (фиксатор ФАА). Фиксатор разрушает (или растворяет) хлорофилл в хлоропластах. Окраска по Этцольду. Кутикула окрасилась в красный цвет сафронином, ядра эпидермальных клеток - окрасились в сиреневый цвет фуксином, хлоропласты окрасились в синий цвет анилиновым голубым (водорастворимым). Объектив 40х/0,65.
Снимок 3. Парафиновый срез (последовательность обработки: фиксация, обезвоживание, пропитка парафином, резка, депарафинирование, пропитка водой, окраска). В центре снимка устьице. Краситель тот же, что и в предыдущем случае. Рыжий цвет кутикулы от хризоидина. Ядра эпидермы и хлоропласты сиреневые - совместное действие сафранина и анилинового голубого.
Комментарий к файлу: Снимок 1
 Просмотров: 2142
Комментарий к файлу: Снимок 2
 Просмотров: 2142
Комментарий к файлу: Снмок 3
 Просмотров: 2142
|
|
|
|
|
|
|
|
Владимир Деркач
|
|
Регистрация: 12 май 2014 Посты: 30 Откуда: Черкассы
Vk:
|
|
|
|
|
|
|
|